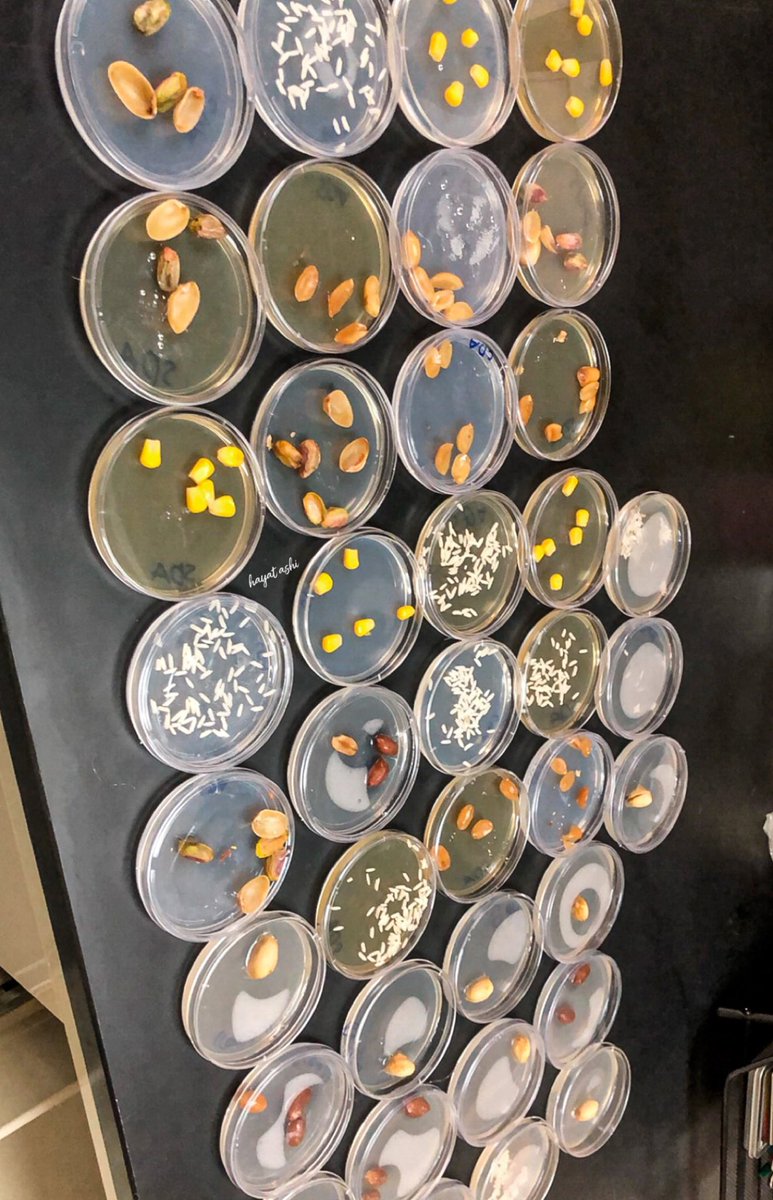
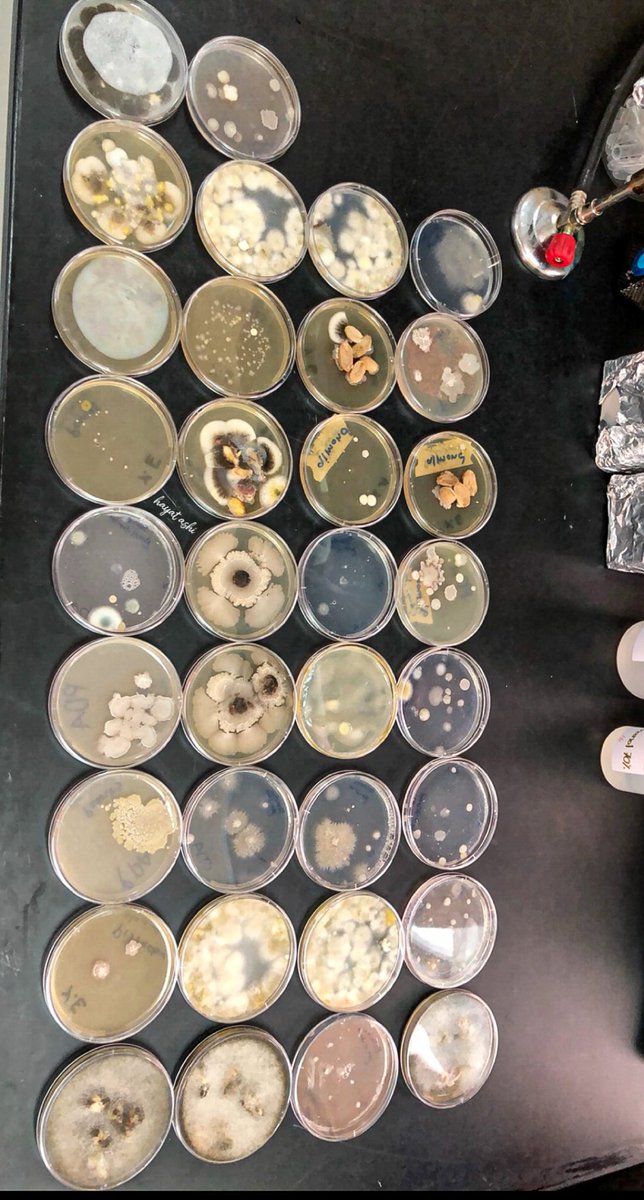
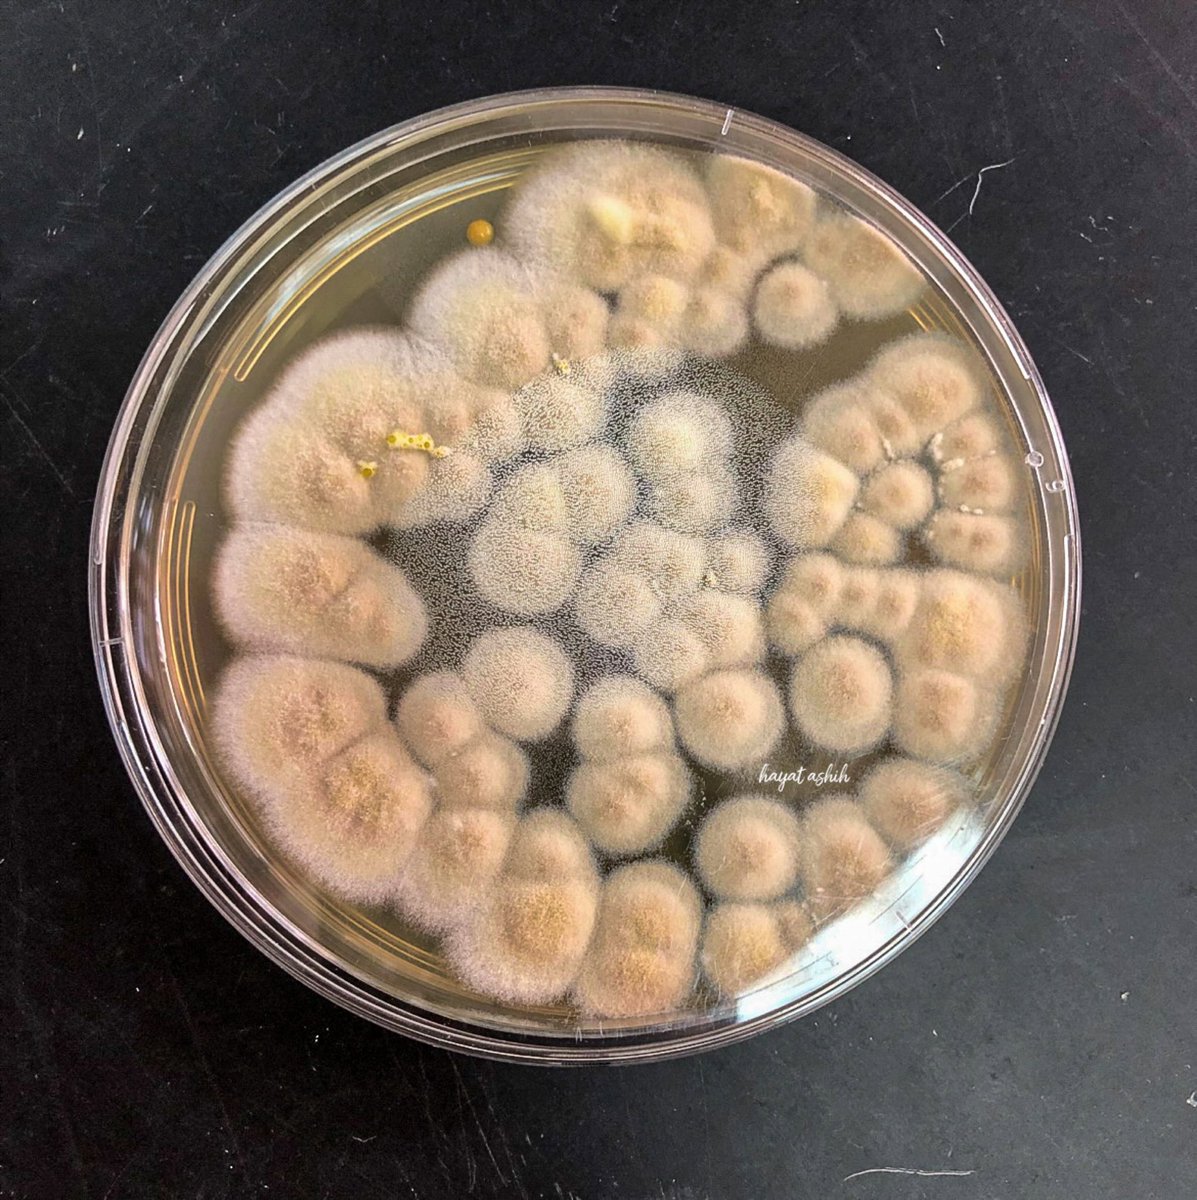
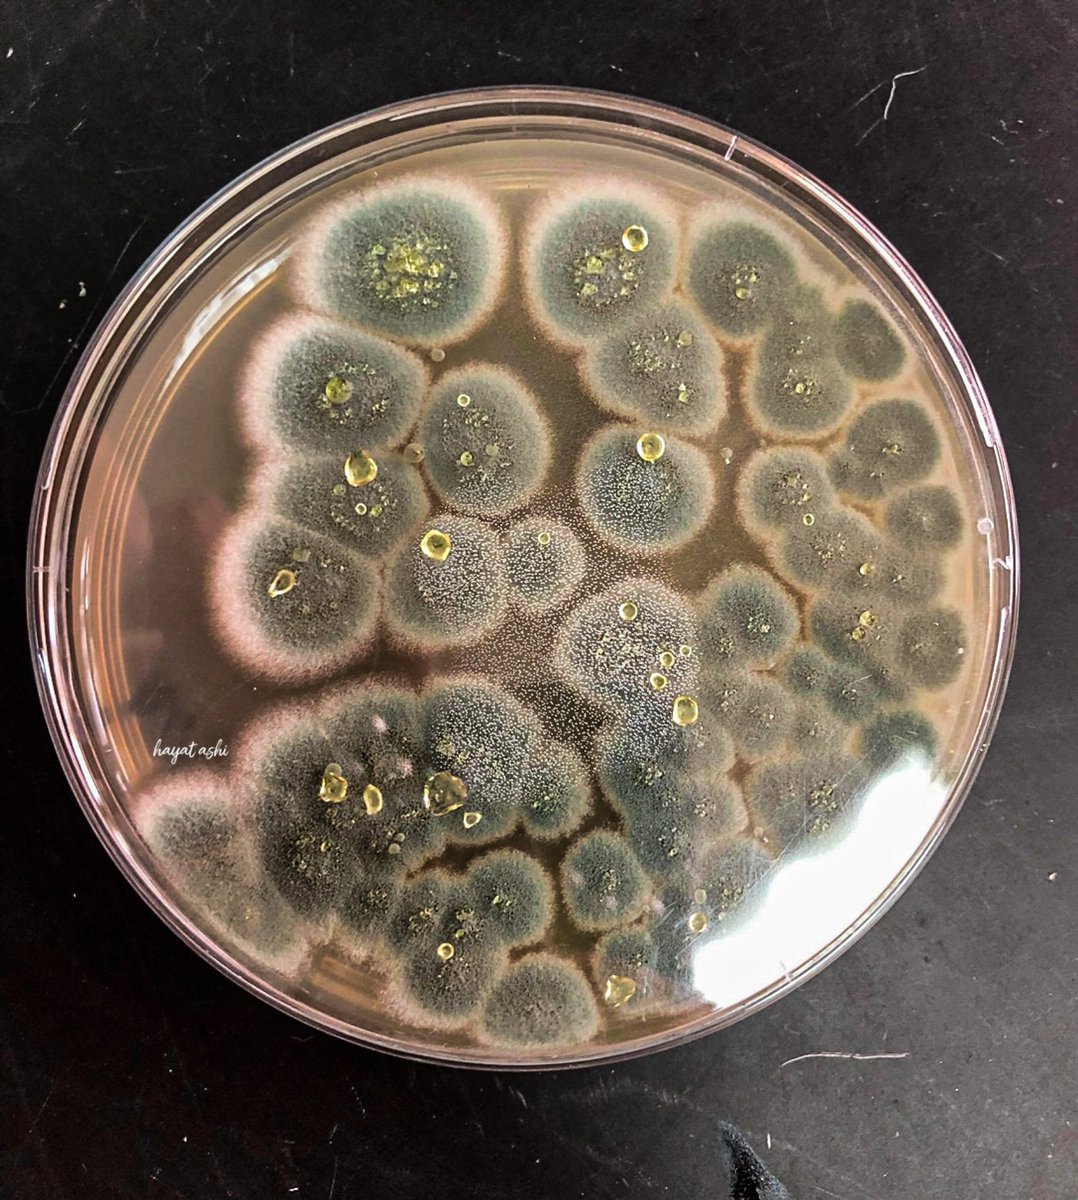

👩🏼🔬معلومة
"كلما زاد التخفيف كلما أمكن الحصول على مستعمرات فطرية نقية"
"تم التخفيف بواسطة @MeshaalAlmalki3 فبوركت جهوده
"كلما زاد التخفيف كلما أمكن الحصول على مستعمرات فطرية نقية"
"تم التخفيف بواسطة @MeshaalAlmalki3 فبوركت جهوده
العزل من الهواء:
1- تحضرأطباق بتري محتوية على بيئة غذائية مناسبة لنمو الفطريات مثل بيئة تشابك دوكس او وسط البطاطا دكستروز اجار او سبرود ميديا
2- يتم كشف غطاء الطبق وتعريض البيئة للهواء لمدة نصف ساعة مثلا مع مراعاة العزل من أماكن مختلفة
1- تحضرأطباق بتري محتوية على بيئة غذائية مناسبة لنمو الفطريات مثل بيئة تشابك دوكس او وسط البطاطا دكستروز اجار او سبرود ميديا
2- يتم كشف غطاء الطبق وتعريض البيئة للهواء لمدة نصف ساعة مثلا مع مراعاة العزل من أماكن مختلفة
- 3تغطى الأطباق ثم تحضن في الحاضنة عند درجة حرارة 25-27م° لمدة ٥-٧ ايام
كما يمكن ايضا ان يتم عزل الفطريات من التربة
كما يمكن ايضا ان يتم عزل الفطريات من التربة
جاري تحميل الاقتراحات...